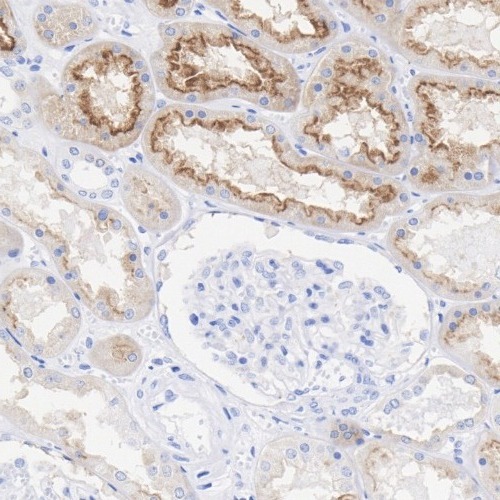
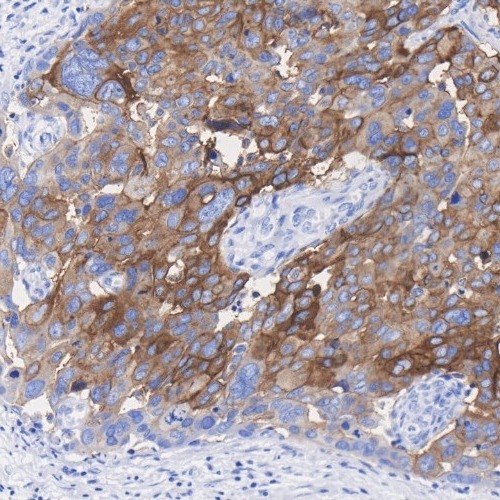

FOLR1 Rabbit Monoclonal Antibody(ARA992)
CAT.NO. : ARA6897
RMB Please choose
RMB Please choose
Background
The protein encoded by this gene is a member of the folate receptor family. Members of this gene family bind folic acid and its reduced derivatives, and transport 5-methyltetrahydrofolate into cells. This gene product is a secreted protein that either anchors to membranes via a glycosyl-phosphatidylinositol linkage or exists in a soluble form. Mutations in this gene have been associated with neurodegeneration due to cerebral folate transport deficiency. Due to the presence of two promoters, multiple transcription start sites, and alternative splicing, multiple transcript variants encoding the same protein have been found for this gene.
Application
|
Application |
Dilution Ratio |
|
WB |
1:1000-1:5000 |
|
IHC-P |
1:500-1:2000 |
Overview
|
Antibody Type |
Recombinant Rabbit monoclonal Antibody |
|
Immunogen |
Recombinant protein within human FOLR1 aa 25-257. |
|
Species Reactivity |
Human |
|
Validated Applications |
WB, IHC-P, IF |
|
Molecular Weight |
Predicted band size: 30 kDa |
|
Positive Control |
HeLa cell lysate, JAR cell lysate, human kidney tissue, human ovary cancer tissue. |
|
Conjugation |
unconjugated |
|
Form |
Liquid |
|
Storage Buffer |
PBS (pH7.4), 0.1% BSA, 40% Glycerol. Preservative: 0.05% Sodium Azide. |
|
Isotype |
IgG |
|
Purification Method |
Protein A affinity purified. |
Data

Western blot analysis of FOLR1 on different lysates with FOLR1 Rabbit Monoclonal Antibody(ARA992).
Immunohistochemical analysis of paraffin-embedded human kidney tissue with FOLR1 Rabbit Monoclonal Antibody(ARA992).
Immunohistochemical analysis of paraffin-embedded human ovary cancer tissue with FOLR1 Rabbit Monoclonal Antibody(ARA992).
Storage
Store at 4°C short term. For long term storage, store at -20°C, avoiding freeze/thaw cycles.
Research Use Only
For Research Use Only. Not for use in diagnostic procedures.
New Products
